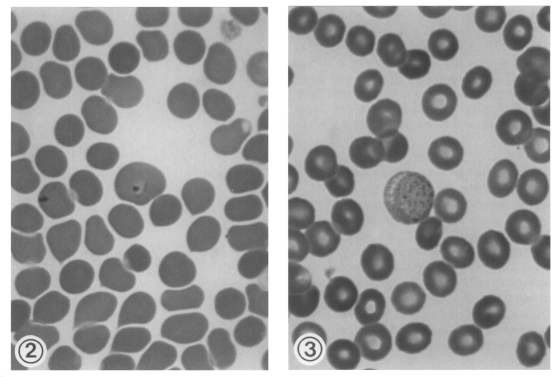
1

Abstract
Plasmodium vivax malaria, which was highly prevalent in the Republic of Korea, disappeared rapidly since 1970s. However, malaria re-emerged with the first occurrence of a patient in 1993 near the demilitarized zone (DMZ), the border between South Korea and North Korea. Thereafter, the number of cases increased exponentially year after year, totaling 6,142 cases (6,249 if United States Army personnels were included) by the end of 1998. Interestingly enough, the majority of cases (3,743; 61%) was soldiers aged 20-25, camping around the northern parts of Kyonggi-do or Gangwon-do (Province) just facing the DMZ. Among 2,399 civilian cases, 1,144 (47.7%) were those who have recently retired from their military services in the northern parts of the two Provinces. The re-emerging malaria characteristically revealed a combination type of short and long incubation periods with predominance of the long type. The course of illness was relatively mild, and the treatment was successful in most patients. Vector mosquitoes are Anopheles sinensis and possibly A. yatsushiroensis. Wide-scale preventive and control measures should be operated to eradicate this re-emerging disease. It has been suggested by many authors that the initial source of the re-emerging malaria was infected mosquitoes which had flown from the northern part of the DMZ.
-
Key words: Plasmodium vivax, malaria, re-emergence, soldiers, northern parts of Kyonggi-do and Gangwon-do, short and long incubation periods
INTRODUCTION
Korea has been politically divided into two countries since 1945; South Korea (the Republic of Korea) and North Korea (the Democratic People's Republic of Korea). In the meantime, the Korean War broke out in 1950 and continued for 3 years. After a cease-fire line was formed in 1953, it became an international border, which is now called as the demilitarized zone (DMZ). The DMZ is a 4-km-wide and 250-km-long corridor extending across the middle part of the Korean peninsula (
Kim, 1997). No civilians have been allowed to enter into the DMZ for longer than 50 years, so that the DMZ areas are highly preserving not only the natural landscapes but also their own ecosystems and biodiversity (
Kim, 1997).
Until the 1970s, tertian malaria due to
Plasmodium vivax was highly prevalent in the Republic of Korea (
Soh et al., 1985;
Paik et al., 1988). Since then, malaria disappeared rapidly, and no indigenous cases were reported after 1984 (
Soh et al., 1985;
Chai, 1997). In 1993, however, a young soldier who apparently had no history of traveling abroad was found to be infected with
P. vivax near the DMZ (
Chai et al., 1994). Since then, the number of cases has increased exponentially year after year, totaling 6,142 cases (6,249 cases if 107 United States Army personnels were included) by December 1998 (
National Institute of Health, Korea, 1995-1999). This paper briefly reviews historical backgrounds of malaria in the Republic of Korea, and characteristics of re-emerging malaria in various aspects.
HISTORICAL REVIEWS
Old documents on malaria
Malaria, which is called "Hak-chil" in Korean, is believed to be endemic for many centuries in Korea (
Paik et al., 1988). There was a first brief note on the occurrence of malaria in 1152 (King Eui-Jong, Koryo Dynasty) and another in 1278 (King Choong-Yul, Koryo Dynasty) (
Chu, 1986). A detailed description was made on the occurrence of malaria among the royal family in 1420 (King Sei-Jong, Yi Dynasty), stating that King's mother and King's brother Yang-Nyung suffered from repeated episodes of malaria (
Chun and Kim, 1959). Also in 1526 (King Sun-Jo, Yi Dynasty), there was a record of a big malaria outbreak in Kyongsang-do (
Chun and Kim, 1959).
Plasmodium vivax,
P. falciparum, and
P. malariae have been reported from the Korean residents. However, it is generally accepted that the only indigenous species which had prevailed in the past and re-emerged recently is
P. vivax (
Chun and Kim, 1959;
Paik et al., 1988;
Chai, 1997).
On the other hand, syringe-borne infections with
P. falciparum or
P. malariae were reported among narcotic addicts (
Seo and Rim, 1959). According to the report, out of 1,404 patients examined in the Seoul City Narcotic Addicts Hospital, 102 (7.3%) were found to be positive for either
P. falciparum or
P. malariae (
Seo and Rim, 1959).
The first scientific document on malaria occurrence was published in 1913 (
Hasegawa, 1913). In the paper, a total of 1,343 cases of
P. vivax malaria was collected from all over the country, including 1,201 Koreans and 142 Japanese. At that time, malaria occurred throughout the country without noticeable geographical differences. In the 1920s, however, the number of malaria cases slightly decreased (
Kobayashi, 1926) and began to localize slowly in specific localities (
Himeno, 1926;
Kodama, 1928;
Kobayashi, 1931).
Also in the 1930s, malaria incidence decreased year after year (
Choy, 1936), and seemingly the decreasing tendency continued slowly until the 1940s. However, malaria must have been continuously a big health threat, considering the fact that, out of 3,983 children studied in Seoul, 584 (14.7%) were found to have suffered from malarial attacks during the year 1948 (
Chun and Kim, 1959).
Despite lack of surveillance data, it was fully agreed that malaria situation became much worse after the Korean War which broke out in 1950 (
Paik and Tsai, 1963). An example of the worsened situation could be seen through 6,311 army soldiers examined; 1,044 (16.5%) had episodes of febrile illness due to malaria during 6 months in the year 1950 (
Chun and Kim, 1959). Similarly, in a small town of Yangyang-gun, Kangwon-do, as many as 1,093 malaria patients had occurred during 6 months of the year 1952 (
Chun and Kim, 1959). Among military personnels, the Korean Army medical record reported 8,855 malaria cases in 1953 and 5,741 cases in 1954 (
Paik and Tsai, 1963). It is worthwhile to note that 152 (11%) out of 1,350 Canadian veterans who fought in the Korean War during the year 1952 developed malaria after returning home (
Hale and Halpenny, 1953). This also supports the spread of malaria during the Korean War.
The status of malaria seems to have improved a little after the war until the end of the 1950s. However, there still remained many scattered endemic foci all over the country. For example, a local study performed in 1959 reported a high annual incidence (11.5%) of malaria among 1,700 school students in Yongju-gun, Kyongsangbuk-do (
Lee, 1960).
To cope with the problem of malaria, National Malaria Eradication Service (NMES) was established under the government control in collaboration with the World Health Organization (WHO). A national wide-scale survey on the parasite index was performed in 1960. A total of 18,697 blood smears was collected randomly from 278 nationwide areas (=small villages), and 212 (1.1%) were found positive for
P. vivax (
Ministry of Health and Social Affairs, Korea, 1966;
Paik et al., 1988).
As the parasite positive rate in the survey was generally low and the method described above didn't appear to be sensitive enough to assess malaria situations accurately, a passive case detection (PCD) method was employed (
Ministry of Health and Social Affairs, Korea, 1966). During the period between 1961 and 1965, a total of 45,395 febrile cases was reported by the PCD agents, and the blood smears were received by the NMES.
Microscopy of the blood smears revealed 13,929 positive cases (30.7%) of
P. vivax (
Ministry of Health and Social Affairs, Korea, 1966). The largest number of positive cases was detected from Kyongsangbuk-do (8,522 of 20,526 examined; 41.5%) followed by Kyonggi-do (3,831 of 12,501 examined; 30.6%) and Gangwon-do (680 of 2,077 examined; 32.7%). However, owing to the disease control operated by the NMES and to the gradual elevation of socioeconomic conditions of the Koreans, malaria endemicity declined year after year, retaining only a few endemic foci in scattered areas.
It is noteworthy that a map of active transmission areas was established at the end of 1965 by the NMES (
Fig. 1). According to the map, only 10 counties in Kyongsangbuk-do and 10 counties in Kyonggi-do were acknowledged as the active transmission areas (
Paik et al., 1988).
In the early 1970s, malaria began to disappear very quickly, not only from the low endemic areas, but also from the high endemic areas such as Kyongsangbuk-do and Kyonggi-do. For example, the blood samples taken from two counties in Kyonggi-do (Yoju-gun and Yangpyong-gun) in 1972, where endemicity in 1964 was noticeably high, showed a remarkable decrease in the number of parasite positive cases. Only 4 out of 432 febrile patients examined were positive (
Lee et al., 1972). Another report, which analyzed 107 malaria cases diagnosed in 26 large hospitals during 1970-1985, showed only 27 indigenous cases (
Soh et al., 1985). It was also shown that the number of indigenous cases decreased year by year; 15 in 1970-1973, 8 in 1974-1977, 2 in 1978-1981, and 2 in 1982-1984 (
Soh et al., 1985). The last two cases in 1984 became the last record of indigenous malaria before malaria re-emerged in 1993 (
Chai et al., 1994).
Two species of anopheline mosquitoes,
Anopheles sinensis and
A. yatsushiroensis, were confirmed to be the vector hosts capable of transmitting
P. vivax in Korea (
Ree et al., 1967;
Hong, 1977). In endemic areas,
A. sinensis was usually the dominant species, hence, recognized as the main vector. In mountainous areas, however,
A. yatsushiroensis may also have played an important role for a vector host (
Paik et al., 1988).
Anopheles sinensis had long been suspected as a vector for
P. vivax in Korea (
Kobayashi, 1931). However, with the discovery of sporozoites from one of 7,517
A. sinensis mosquitoes dissected, it was verified to be the vector for the first time (
Ree et al., 1967). As for
A. yatsushiroensis, one out of 1,469 mosquitoes dissected was found to be infected with oocysts of
P. vivax (
Hong, 1977).
Imported malaria
Imported malaria has been frequently reported in the Republic of Korea (
Kim, 1967;
Seo et al., 1970;
Ahn et al., 1982;
Soh et al., 1985;
Lee, 1989). One of the important documents is a paper reporting 235 malaria patients who returned home from South Vietnam after the Vietnam War (
Seo et al., 1970). Most of them (224 cases; 95.3%) were infected with
P. falciparum alone, while one case (0.4%) was infected with
P. vivax and the remaining 10 (4.3%) were infected with both
P. falciparum and
P. vivax.
Another paper, which analyzed 107 malaria cases diagnosed in 26 large hospitals during 1970-1985, reported that 80 cases were imported malaria from Africa, Middle East, and Southeastern-Pacific Regions (
Soh et al., 1985). The species of imported malaria included mostly
P. falciparum and
P. vivax, and only one case of
P. ovale infection was diagnosed from a Malaysian (
Soh et al., 1985). The reason for the rarity of
P. malariae among the imported cases is uncertain.
An interesting history in the study of the Korean (=North Korean) strain of
P. vivax is that it was used for human experimental infections; to psychiatric patients who were undergoing malaria therapy in Moscow, Russia (
Tiburskaja and Vrublevskaja, 1977;
Collins et al., 1985). It is also of great interest that the North Korean strain of
P. vivax has been maintained in the laboratory in western countries using anopheline mosquitoes and splenectomized chimpanzees for at least 30 years (
Krotoski et al., 1982;
Collins et al., 1985). The origin of the parasite was from a North Korean who developed malarial fever on his visit to Moscow (
Tiburskaja and Vrublevskaja, 1977).
One of the important information obtained by the researchers is as follows. The North Korean strain of
P. vivax revealed a peculiar feature in their incubation period. Out of 77 persons experimentally infected, 19 (24.7%) revealed short incubation periods of less than 1 month, and 58 (75.3%) revealed prolonged incubation periods ranging from 5 to 13 months (
Table 1) (
Tiburskaja and Vrublevskaja, 1977). In explaining the difference in the incubation periods, it was suggested that the number of sporozoites inoculated could have been a factor (
Shute et al., 1976). According to them, there must be two different populations of sporozoites that are genetically programmed to produce either a short or a long incubation period. The proportion of the short type sporozoites was thought to be low, less than one per 1,000 sporozoites (
Shute et al., 1976). Hence, unless a person is infected with a large number of sporozoites, he will have a greater chance to undergo a prolonged incubation.
Another interesting observation is that the North Korean strain of
P. vivax revealed frequent relapses, unless drugs for treatment of tissue stages were given (
Tiburskaja and Vrublevskaja, 1977). Twenty-three (31.1%) out of 74 patients treated with blood schizontocidal drugs showed relapses, and the interval between the end of the treatment of primary attacks and the onset of relapses was, interestingly, two types: short (< 4 months; in 17 patients) and long (5-13 months; in 19 patients).
RE-EMERGENCE AND EPIDEMIC OUTBREAK OF MALARIA
First re-emergence of malaria
In July 1993, a young soldier working near the DMZ developed periodic fever every other day and was admitted to the Capital Armed Forces General Hospital. The blood smears revealed typical ring forms, trophozoites, and gametocytes of
P. vivax (
Figs. 2-3). He had never been abroad, thus, the possibility of imported malaria was ruled out. He was treated successfully with hydroxychloroquine and primaquine, and follow-up blood smears revealed no parasites (
Chai et al., 1994).
Possible reasons and the origin of the occurrence of
P. vivax infection in this patient were discussed, and three possibilities were raised. One was a natural transmission from relapsed or long-term latent infection of indigenous cases in Paju area, where malaria endemicity was very high in the past. However, this possibility was weak. The second was an introduced malaria transmitted by imported cases, but once again, this possibility lacked validity. The third was an introduction of infected mosquitoes from the northern part of the DMZ, and this possibility seemed plausible. However, it could not be confirmed since the information regarding the malaria situation in North Korea was lacking (
Chai et al., 1994).
Soon after the first occurrence, two vivax malaria patients had been diagnosed consecutively in June and July, 1994 (
Cho et al., 1994). One was a male soldier serving near the DMZ, and the other was a female house guardian working within 4 km from the DMZ. Both of them had no history of traveling abroad.
Immediately after then, 20 more cases occurred from July to October, 1994, all of which, except for the housewife, were soldiers who worked near the DMZ (
Chai, 1996,
1997). Therefore, 22 cases in total occurred among the Korean people during the year 1994 (
Table 2;
Figs. 4,
5). Additionally, one malaria case occurred in 1994 among the United States (US) Army soldiers working in the northern part of Kyonggi-do (
Table 2).
Explosively increasing numbers of malaria cases have been reported thereafter (
Table 2;
Figs. 4,
5). In 1995, a total of 107, which include 88 soldiers, 11 retired soldiers who had worked near the DMZ within 1 year, and 8 civilians, was reported. The number of cases among Koreans increased rapidly and remarkably to 356 in 1996, to 1,724 in 1997, and to 3,932 in 1998 (
National Institute of Health, Korea, 1996-1999), showing a typical exponential curve in the annual incidence (
Fig. 4). Additionally 1, 12, 47, and 46 patients occurred respectively in each year during the period of 1995-1998 among US military personnels during their military services in Korea (total 62 cases) or after returning home (total 45 cases) (
Table 2).
The majority of the patients were soldiers and veterans who served near the northern part of Kyonggi-do until 1996. However, an apparent tendency was noted that the proportion of civilian cases increased up to 20-25% in 1997-1998 (
Table 2).
Until 1994, the outbreak areas of the re-emerging malaria were limited to Paju-gun and Yonchon-gun, Kyonggi-do, both of which are located within 10-15 km from the southern border of the DMZ (
Fig. 5) (
Chai, 1997). However, the outbreak areas are undoubtedly expanding both southwards and eastwards each year (
Fig. 5). During 1995-1996, more patients occurred in other southern parts of Kyonggi-do, and even in the eastern parts of the two original counties (
Fig. 5); Kimpo-gun, Koyang-gun, Yangju-gun, Pochun-gun, Dongduchon (Kyonggi-do), and Chorwon-gun (Gangwon-do) (
Chai, 1997;
Kim DI et al., 1998;
Kho et al., 1999).
During 1997-1998, the outbreak areas expanded more widely, and Inchon (western city), Kangwha-gun (Kyonggi-do), and Gosong-gun, Gumchon-gun, Yanggu-gun, Inje-gun, and Hwachon-gun (Gangwon-do), were newly included to the areas of malaria outbreak (
Noh, 1998). Meanwhile, a substantial number of patients occurred in areas remote from the major outbreak areas, such as Pusan, Taegu, and Kwangju (
Fig. 5). Such cases increased remarkably in their numbers in 1998 (
Fig. 6). The majority was either veterans who recently retired from the military services or travelers who came across the outbreak areas, while the rest had no such history (
Lee et al., 1998). No matter which category they fell into, they could be a possible source of secondary transmission (
Singal et al., 1977), so they should be considered of a great epidemiologic significance.
EPIDEMIOLOGICAL CHARACTERISTICS OF RE-EMERGING MALARIA
Origin of re-emergence
Although three possibilities were raised for the reasons of malarial re-emergence (
Chai et al., 1994), it is now unanimously agreed that the re-emerging malaria originated from the northern part of the DMZ (
Chai, 1997,
1998;
Kho et al., 1999). It seems like a typical example of border malaria (
Karbwang and Harinasuta, 1993;
Xu and Liu, 1997). However, unlike the border malaria reported in other countries, there is a peculiar feature in the present malaria. It is presumed to have been originated, not by immigration of infected people from the north, but by infected mosquitoes which had flown from the north.
It was suggested that, not only in the first few hundreds of cases, but also in the great majority of patients reported during 1994-1997, the main malaria contraction was by infected mosquitoes which flew in from the northern part of the DMZ (
Kho et al., 1999). Similarly, two middle school children who suffered from malaria in Kimpo-gun were suggested to have been infected by mosquitoes originated from elsewhere (
Lee et al., 1997). The above suggestions may be partially true. Even at present, it seems likely that a considerable number of infected mosquitoes are flying in from the northern part of the DMZ and infect people in the Republic of Korea. However, there is no scientific evidence with practical data yet.
It seems possible that the infected mosquitoes travel from the north, over the DMZ, to the south if there is a favorable wind condition which helps mosquitoes to travel far. However, the flying distance of the vector mosquito,
A. sinensis, is generally known to be shorter than 5 km (
Shim and Kim, 1999), rarely over 10 km, and the full width of the DMZ is about 4 km. Therefore, migration of mosquitoes across the border could be possible only in a fraction of mosquitoes.
Moreover, even in endemic areas, the mosquito population infected with malaria is known to be very small in proportion, only one per 1,469
A. yatsushiroensis (
Hong, 1977) or only one per 7,517
A. sinensis mosquitoes (
Ree et al., 1967). Also,
A. sinensis is known to be highly zoophilic rather than anthropophilic (
Ree, 1998). Accordingly, migration of at least 10,000,000, or more, mosquitoes are needed to infect 1,000 patients in the Republic of Korea. Long distance migration of so large a number of
A. sinensis mosquitoes across the border seems rather impossible under natural conditions.
It would be reasonable, therefore, to regard the current sources of the re-emerging malaria as two kinds; infected mosquitoes migrating from the north as well as mosquitoes infected locally by secondary transmissions in the south. Especially the patients infected in areas farther than 10-20 km southwards from the border are more likely to have been infected by locally bred and locally infected mosquitoes. A greater part of the patients infected in areas within 5-10 km from the border could have been infected by the ones that migrated from the northern part of the DMZ.
Possibility of secondary and tertiary transmissions
Possibility of secondary and tertiary transmissions in the Republic of Korea has been put to questions by several authors (
Ree, 1998;
Kho et al., 1999). It was argued that the environmental and socio-economic standards of the people in the south are so high that secondary, tertiary transmissions, and settlement of malaria would be less possible (
Ree, 1998).
Introduced malaria by secondary transmissions from a single index case, however, is not uncommon in other countries; for example, more than 10 times occurrence of introduced malaria was reported in the US (
Singal et al., 1977). Small outbreaks of malaria in previously non-endemic areas were also reported from the US (
Singal et al., 1977) and Trinidad W.I. (
Chadee et al., 1992).
As for the re-emerging malaria in the Republic of Korea, secondary and tertiary transmissions could occur not only in the outbreak areas, northern parts of Kyonggi-do and Gangwon-do, but in remote areas where patients with long incubation periods immigrated.
It is worthwhile to note that 32 (4.9%) of 650 civilian patients reported during 1994-1997 revealed no history of working or traveling to the outbreak areas (
Lee et al., 1998). Probably those cases were infected locally by secondary or tertiary transmissions. Other examples suggesting secondary transmissions are numerous. One of them is an interesting report of two malaria patients in children aged 7 and 5 living in Ilsan City, Kyonggi-do, the suburbs of Seoul (
Kwak et al., 1997). Both children had history of visiting Pochun-gun, a low risk area where only a very limited number of patients occurred before 1997 (
Lee et al., 1998). But the duration of their stay in Pochun-gun was very short (i.e., only half day) to be contracted with malaria. Another example is the occurrence of several malaria patients from the eastern remote areas such as Gosong-gun and Yanggu-gun, Gangwon-do. They had no history of visiting the outbreak areas (
Noh, 1998).
Occurrence of secondary transmissions does not necessarily mean settlement of the re-emerging malaria. Unless tertiary, quarterly and further transmissions occur continuously, the force of transmission will become weak and malaria will finally disappear.
In relation to settlement of malaria in the Republic of Korea, there is an optimistic view (
Ree, 1998). It was argued that, due to the high standard of living, poor vectorial capacity of
A. sinensis (highly zoophilic), prompt medical care, and short transmission period (around summer season only), it would not be possible for the re-emerging malaria to settle and become endemic (
Ree, 1998).
This arguement may be true. However, it is the author's speculation that the re-emerging malaria will continue to prevail for some time, then equilibrate, followed by a quick declination. But this speculation could be done only under two conditions. First, an active eradication programme is to be operated in a nationwide scale in the Republic of Korea. Second, malaria situation in the northern part of the DMZ should be quickly improved.
Transfusion malaria
It is well known that army soldiers are important candidates as blood donors in the Republic of Korea. It is also known that the majority of the re-emerging malaria cases are soldiers (
Chai, 1998). Therefore, a high risk of transfusion malaria was raised and warned (
Lim et al., 1997). Fortunately, however, there was only one document reporting a case of fever of unknown origin, which was later confirmed as a transfusion malaria (
Jeong et al., 1999).
A prominent seasonal pattern was observed in the incidence of febrile paroxysms due to the re-emerging malaria (
Fig. 7) (
Chai, 1997). The mid-summer to mid-autumn (i.e. July to October) was the peak season for the outbreak of patients. The seasonal pattern must be related to the incubation period of each patient. It has been repeatedly reported that the Korean (= North Korean) strain of
P. vivax revealed two types of incubation periods; a short incubation period of less than one month and a long incubation period of which the period varies from 5 to 13 months (
Shute et al., 1976;
Tiburskaja and Vreblevskaja, 1977).
Considering these two types of incubation periods, the actual contraction of malaria through mosquito bites must occur between the early summer and the early autumn seasons (June-September). Most of the cases occurring during the winter and spring seasons are, therefore, considered to be infected during the active transmission seasons in the previous year.
When the seasonal incidence of the re-emerging malaria was compared with that of an old report in Korea (
Hasegawa, 1913), the pattern was generally the same with each other (
Fig. 7). This could be a circumstantial evidence that the re-emerging malaria is not caused by imported cases, but by transmission of border malaria from the northern part of Korea.
It is well known that anopheline mosquitoes, namely
A. sinensis and
A. yatsushiroensis, are the vector hosts capable of transmitting
P. vivax malaria in Korea previously (
Paik et al., 1988). After the re-emergence of
P. vivax malaria, however, few studies have been conducted on vector mosquitoes, and no official documents have been published demonstrating the species of mosquitoes responsible for the transmission of re-emerging malaria.
Meanwhile, mosquito population studies were performed in the outbreak and non-outbreak areas (
Shim et al., 1997). It was shown that
A. sinensis was one of the most popularly collected species in all of the four areas surveyed, and its population density was higher in outbreak areas than in non-outbreak areas. The peak season in the population density of
A. sinensis was July. It was also demonstrated that
A. sinensis was the most popular species among the human-biting mosquito species.
CLINICAL CHARACTERISTICS OF RE-EMERGING MALARIA
Incubation period
The re-emerging
P. vivax malaria reveals a unique feature in their manifestation of the incubation period; many patients showed prolonged incubation periods (
Kho, 1998;
Kim DI et al., 1998;
Kim EO et al., 1998;
Lee et al., 1998). A questionaire study performed on the incubation period of 107 veterans, who developed malaria after their retirements from the military services, revealed that the incubation period was as long as 279 ± 41 days (range; 153-452 days) (
Lee et al., 1998). Similarly, 272 ± 36 days (range; 217-351 days) were obtained from 36 patients who had shown prolonged incubation periods (
Kho, 1998). According to another paper (
Kim EO et al., 1998), out of 12 patients whose past histories were successfully taken, the proportion of the cases with short incubation periods was 25% (3 patients; 2-3 weeks) while the rest (75%) showed long incubation periods (9 patients; 5-12 months).
This feature agrees very well with the report of an old literature on the Korean strain of
P. vivax (
Hasegawa, 1913). It states that 6 Japanese soldiers returning to Osaka, Japan, after their military services in Korea, developed malarial paroxysms when there was no malaria outbreak. Another example is the development of malarial fever upon returning home in 152 (11%) out of 1,350 Canadian veterans who fought in the Korean War during the year 1952 (
Hale and Halpenny, 1953). Also, the results of human experimental studies with the North Korean strain of
P. vivax (
Tiburskaja and Vrublevskaja, 1977) strongly support the above unique feature.
Many studies were performed on the clinical features of the re-emerging malaria such as fever patterns. The first case which occurred in 1993 (
Chai et al., 1994) and the second in 1994 (
Seo et al., 1995) revealed typical 48-hr interval periodic fevers (
Fig. 8). A similar finding was also reported. Out of 26 soldiers with malaria, 21 showed typical fever interval of 48 hr, 4 showed irregular intervals initially but later changed into 48-hr intervals, and the remaining one revealed irregular intervals (
Kim and Lim, 1997).
Frequent occurrence of atypical fever intervals was also reported. According to a paper which analyzed 87 re-emerging malaria cases, 61 showed typical regular fevers of 48-hr interval, whereas 26 showed fever curves atypical for
P. vivax; 24-hr interval (10 patients) or irregular intervals (16 patients) (
Yim et al., 1996).
The duration of one febrile paroxysm was reported as 4 hr and 20 min on average (range; 1 to 8 hr) among 26 soldier patients (
Kim and Lim, 1997).
Anemia is one of the typical clinical features in all types of malaria. However, anemia was not popular in most of the re-emerging
P. vivax patients. For example, except in a few cases (
Kim MY et al., 1998), the majority of patients showed only slightly decreased hemoglobin and hematocrit levels or even no signs of anemia (
Lim et al., 1996;
Yim et al., 1996;
Kim and Lim, 1997;
Kho, 1998).
One of the peculiar hematological features of the re-emerging malaria is a high incidence of thrombocytopenia; 72.4% of 87 patients (
Lim et al., 1996), 61.5% of 26 patients (
Kim and Lim, 1997), 85% of 114 patients (
Kho, 1997), and 100% of 15 patients (
Kim EO et al., 1998). Consequently, platelet counts were reported as a useful index for the post-treatment follow-up of the re-emerging malaria patients (
Lim et al., 1998). In the number of white blood cells, either leukocytosis or leukopenia was noted (
Kim and Lim, 1997).
The uncommon occurrence of asymptomatic latent infections is another clinical characteristic of the re-emerging malaria. For example, a young lady suffered from a mild and transient fever and chill, but she underwent subclinically without developing any symptoms for 7 weeks before parasitemia was detected; instead, she mimicked thrombocytopenic purpura (
Park et al., 1998). It was also noteworthy, in an endemic field of the northern part of Kyonggi-do, that two (1.6%) of 137 inhabitants examined were positive for parasitemia without any clinical symptoms (
Kho, 1998). Undoubtedly, these cases could play a role for the source of secondary transmissions to other people.
It is already known that, unless drugs for the treatment of tissue stages were given, the North Korean strain of
P. vivax relapsed frequently (
Tiburskaja and Vrublevskaja, 1977). The reason for the frequent relapse of
P. vivax malaria, including the North Korean strain, was analyzed, and a new hypothesis was proposed (
Krotoski, 1985). According to the hypotheis, the relapse of
P. vivax malaria may be due to the mixture of sporozoites having different capability to undergo hepatic schizogony; some are capable to make schizonts quickly, but others need longer times to complete schizogony. The latters can lead to prolonged incubation periods as well as repeated relapses (
Krotoski, 1985).
However, the re-emerging
P. vivax malaria has shown very few relapsed cases (
Kim EO et al., 1998). It is undoubtedly owing to successful treatments of almost all patients with standard combination therapy of chloroquine and primaquine, if diagnosed accurately as
P. vivax (
Kim EO et al., 1998).
The course of illness was relatively mild and prognosis was fairly good in most patients. Drug resistance of the re-emerging P. vivax has not been reported. Also, according to the available current literature, no mortality has been reported.
PREVENTION AND CONTROL
Various measures for prevention and control of the re-emerging malaria have been operated on military personnels (
Lee, 1998). Personal protection from mosquito bites, establishment of a surveillance system with early detection and treatment of patients, control of mosquitoes using pesticides, prohibition of blood donation by soldiers serving in outbreak areas, health education, and chemoprophylaxis have been the major strategies. However, the measures undertaken so far have been unsuccessful since the epidemic continued.
As for the civilians, a small surveillance system was operated in Paju-gun, the most important outbreak area, and detected 24.5% parasite positive rate among 94 febrile patients by the PCD method (
Kim DS et al., 1997). However, no other report is available on the operation of a wide-scale surveillance system and eradication programmes targeted at civilians.
It is the author's speculation that, if proper wide-scale eradication programmes are operated, the re-emerging malaria will decline very quickly. An important variable for the success of the control programmes is undoubtedly the malaria situation in the northern part of the DMZ, since mosquitoes flying from the north are playing the role for an important source of the infection every year (
Kho et al., 1999).
We have to keep in mind, however, that once malaria has re-emerged in an area it is not so easy to make it disappear completely. It is referable to that, in the United Arab Emirates, more than 15 years were needed to obtain a significant reduction of malaria incidence in a zone of re-emerged unstable malaria (
Dar et al., 1993).
CONCLUSIONS AND RECOMMENDATIONS
Tertian malaria due to P. vivax infection has re-emerged in the Republic of Korea since 1993, and the epidemics are occurring every year. The initial and a part of current source of the infection is presumed to be mosquitoes migrating from the northern part of the DMZ, the border between South Korea-North Korea. Therefore, the re-emerging malaria is regarded as a peculiar type of border malaria; transmission by migration of infected mosquitoes only. However, it cannot be completely ruled out that the re-emerging malaria could settle, producing substantial numbers of secondary and tertiary transmission cases. Establishment and operation of a nation-wide eradication programme are urgently recommended.
ACKNOWLEGEMENTS
The author would like to thank Prof. Soon-Hyung Lee, Department of Parasitology, Seoul National University College of Medicine, who encouraged preparation of this review and gave critical comments on the manuscript. The author is indebted to Dr. Hee-Choon S. Lee, Preventive Medicine Officer, 18th Medical Command, 8th US Army, Korea, for providing information on the number of malaria cases in the US Army personnels. Special thanks are given to the Editorial Committee of The Korean Society for Parasitology who invited this review paper.
References
- 1. Ahn MH, Shin HJ, Im KI, Soh CT. Imported malaria cases in Korea. Yonsei Rep Trop Med 1982;13:23-29.
- 2. Chadee DD, Maitre AL, Tilluckdharry CC. An outbreak of Plasmodium vivax malaria in Trinidad, W.I. Ann Trop Med Parasitol 1992;86:583-590.
- 3. Chai IH, Lim GI, Yoon SN, Oh WI, Kim SJ, Chai JY. Occurrence of tertian malaria in a male patient who has never been abroad. Korean J Parasitol 1994;32:195-200. (in Korean).
- 4. Chai JY. Re-emergence of malaria. Proceed of CME Sem on Infec Dis, Korean Soc of Infec Dis. 1996. p. 109-117 (in Korean).
- 5. Chai JY. Re-emerging malaria. J Korean Med Ass 1997;40:728-733. (in Korean).
- 6. Chai JY. Prospects and control measures of re-emerging malaria in Korea. Proceed of Symp on Recent Re-emerging Dis, Korean Acad Med. 1998. p. 35-43 (in Korean).
- 7. Chiba E, Akai K. On the existence of quartan malaria in Korea. Mansen No Ikai 1930;112:2-19. (in Japanese).
- 8. Cho SY, Kong Y, Park SM, et al. Two vivax malaria cases detected in Korea. Korean J Parasitol 1994;32:281-284.
- 9. Choy D. A case of tropical malaria in Korea. Chosen Igakkai Zasshi 1936;26:491-498. (in Japanese).
- 10. Chu JK. A century history of parasitology in Korea. 1986. Seoul, Korea. Kookje Kyoyok Munwha; p. 1-144 (monograph in Korean).
- 11. Chun CH, Kim JJ. Malaria in Korea. Korean Med 1959;2:63-66. (in Korean).
- 12. Collins WE, Skinner JC, Krotoski WA, et al. Studies on the North Korean strain of Plasmodium vivax in Aotus monkeys and different anophelines. J Parasitol 1985;71:20-27.
- 13. Dar FK, Bayoumi R, Alkarmi T, Shalabi A, Beidas F, Hussein MM. Status of imported malaria in a control zone of the United Arab Emirates bordering an area of unstable malaria. Trans Roy Soc Trop Med Hyg 1993;87:617-619.
- 14. Gong BW. On the presence of tropical malaria in Korea. Chosen Igakkai Zasshi 1936;26:920-922. (in Japanese).
- 15. Hale TR, Halpenny GW. Malaria in Korean veterans. Canad Med Ass J 1953;68:444-448.
- 16. Hasegawa . Malaria in Korea. Chosen Igakkai Zasshi 1913;4:53-69. (in Japanese).
- 17. Himeno K. On the malaria endemicity in Kangnung area in Kangwon-do. Mansen No Ikai 1926;62:59-66. (in Japanese).
- 18. Hong HK. Ecological studies of important mosquitoes in Korea. 1977. Dongkook University Graduate School; p. 1-55 Ph.D Theses. (in Korean).
- 19. Jeong IK, Oh MD, Chai JY, et al. A case of transfusion-induced malaria presenting as fever of unknown origin. Korean J Infec Dis 1999;31:41-45. (in Korean).
- 20. Karbwang J, Harinasuta T. International border malaria control. Southeast Asian J Trop Med Public Health 1993;24:615-616.
- 21. Kho WK. Status of malaria in Korea. Korean J Infec Dis 1997;29:525-530. (in Korean).
- 22. Kho WK. Status of recent outbreak of malaria in Korea. Proceed of Symp on Recent Re-emerging Dis, Korean Acad Med. 1998. p. 9-19 (in Korean).
- 23. Kho WK, Jang JY, Hong ST, Lee HW, Lee WJ, Lee JS. Border malaria characters of reemerging vivax malaria in the Republic of Korea. Korean J Parasitol 1999;37:71-76.
- 24. Kim DH. Epidemiological studies of malaria in Republic of Korean Forces in Vietnam I. Epidemiological observation on the malaria patients. J Korean Med Ass 1967;10:668-678. (in Korean).
- 25. Kim DI, Lee JC, Koo SH. Epidemiological study of malaria outbreak in the DMZ of ROK (II). J Korean Mil Med Ass 1998;29:26-40. (in Korean).
- 26. Kim DS, Kim SD, Yum YT, Lim CS, Lee KR, Park MS, Yoon BJ. Indigenous malaria surveillance in Korea. Korean J Epidemiol 1997;19:180-189. (in Korean).
- 27. Kim EO, Lee MS, Lee SO, et al. Clinical characteristics of malaria in Korean patients. Korean J Infec Dis 1998;30:431-438. (in Korean).
- 28. Kim KC. Preserving biodiversity in Korea's demilitarized zone. Science 1997;278:242-243.
- 29. Kim KH, Lim CS. Clinical observation in 26 cases of indigenous malaria in 1995. Korean J Med 1997;52:577-582. (in Korean).
- 30. Kim MY, Eom KS, Jang T, et al. Clinical analysis of 40 cases of malaria. Korean J Infec Dis 1998;30:180-184. (in Korean).
- 31. Kobayashi H. Malaria in Korea. Nippon No Ikai 1926;16:126-128. (in Japanese).
- 32. Kobayashi H. Characteristics of malaria in Korea. Tokyo Iji Shinshi 1931;2750:2491-2493. (in Japanese).
- 33. Kodama R. On the malaria in Korea. Mansen No Ikai 1928;86:17-30. (in Japanese).
- 34. Krotoski WA. Discovery of hypnozoite and a new theory of malarial relapse. Trans Roy Soc Trop Med Hyg 1985;79:1-11.
- 35. Krotoski WA, Collins WE, Bray RS, et al. Demonstration of hypnozoites in sporozoite-transmitted Plasmodium vivax infection. Am J Trop Med Hyg 1982;31:1291-1293.
- 36. Kwak YH, Choi SE, Na SY, Lee HJ, Chai JY. Two cases of re-emerging indigenous malaria in Korean children. Korean J Ped Infec Dis 1997;4:288-292. (in Korean).
- 37. Lee JM, Kim MY, Kim YR, et al. A small epidemiological survey for vivax malaria in Kimpo-gun, Kyonggi-do, Korea, undertaken after detecting two consecutive cases. Korean J Parasitol 1997;35:291-293.
- 38. Lee JS, Kho WK, Lee HW, Seo M, Lee WJ. Current status of vivax malaria amongcivilians in Korea. Korean J Parasitol 1998;36:241-248.
- 39. Lee KT. Epidemiological survey on malaria at foot-hill region in Kyongsang-puk-do province. Korean J Parasitol 1960;1:67-68. (in Korean).
- 40. Lee MS. Recent (1993-1997) epidemiology and control strategy of malaria in Korean soldiers. Keimyung Med J 1998;17:173-185. (in Korean).
- 41. Lee SH. Imported parasitic diseases in Korea. J Korean Med Ass 1989;32:247-254. (in Korean).
- 42. Lee SW, Shim JC, Kang YB, Ree HI. Investigation of malaria prevalence in Daesin-myon, Yoju-gun, and Kaegun-myon, Yangpyong-gun, Kyonggi-do province. Report of NIH Korea 1972;9:135-138. (in Korean).
- 43. Lim CS, Kim YK, Lee KN. Clinical significance of platelet index in post-treatment follow-up of vivax malaria. Korean J Infec Dis 1998;30:439-442. (in Korean).
- 44. Lim CS, Kim YK, Lee KN, et al. Hematologic findings of reappeared Plasmodium vivax in Korea. Korean J Clin Pathol 1996;16:836-843. (in Korean).
- 45. Lim CS, Kim YK, Lee KN, et al. Risk of malaria transmission by blood donation from army soldiers in Korea. Korean J Infec Dis 1997;29:113-117. (in Korean).
- 46. Ministry of Health and Social Affairs, Korea. Malaria pre-eradication programme in Korea. Progress Report by National Malaria Eradication Service, 1961-1965. 1966. Seoul. p. 44-70 (in Korean with English resume).
- 47. Nakanishi G, Chun CH. Three cases of tropical malaria. Chosen Igakkai Zasshi 1936;26:1126-1127. (in Japanese).
- 48. National Institute of Health, Korea. Communicable Diseases Monthly Report 1995-1999;Vols. 6-10:(in Korean).
- 49. Noh CS. A malaria surveillance system for soldiers and those who will retire soon. Proceed of Sem on Malaria Control, National Institue of Health, Korea. 1998. p. 17-28 (in Korean).
- 50. Oh SN. On quartan malaria in Korea. Mansen No Ikai 1930;112:18-19. (in Japanese).
- 51. Paik YH, Ree HI, Shim JC. Malaria in Korea. Kyung Hee Univ Med J 1988;12:17-31.
- 52. Paik YH, Tsai FC. A note on the epidemiology of Korean vivax malaria. New Med J 1963;6:37-43. (in Korean).
- 53. Park SW, Kim US, Kim HB, et al. A case of asymptomatic Plasmodium vivax malaria mimicking idiopathic thrombocytopenic purpura. Korean J Infec Dis 1998;30:304-307. (in Korean).
- 54. Ree HI. Can malaria be endemic in South Korea? Korean J Infec Dis 1998;30:397-400.
- 55. Ree HI, Hong HK, Paik YH. Study on natural infection of Plasmodium vivax in Anopheles sinensis in Korea. Korean J Parasitol 1967;5:3-4. (in Korean).
- 56. Seo BS, Lee SH, Yoon JJ, Ryang YS. Parasitological studies of Korean Forces in South Vietnam I. Examination of blood filmson malaria patients. Korean J Parasitol 1970;8:25-29.
- 57. Seo BS, Rim HJ. A survey of malaria amongst narcotic addicts in Seoul. Seoul Nat Univ J (Med & Pharm Series) 1959;8:213-220. (in Korean).
- 58. Seo JH, Kim SG, Jung HJ, Kim WJ, Kim MJ, Park SC. A case of Plasmodium vivax malaria occurred in 1994 in Korea. Korean J Infec Dis 1995;27:83-86. (in Korean).
- 59. Sharma VP. Re-emergence of malaria in India. Indian J Med Res 1996;103:26-45.
- 60. Shim JC, Kim DS. Resurgence of the vivax malaria cases in Korea. Korean J Infec Dis 1999;31:25-34. (in Korean).
- 61. Shim JC, Shin EH, Yang DS, Lee WK. Seasonal prevalence and feeding time of mosquitoes (Diptera: Culicidae) at outbreak regions of domestic malaria (P. vivax) in Korea. Korean J Entomol 1997;27:265-277. (in Korean).
- 62. Shiyou H, Nakanishi G, Chun CH. The first case of tropical malaria in Seoul. Chosen Igakkai Zasshi 1936;26:669-680. (in Japanese).
- 63. Shute PG, Lupascu G, Branzei P, et al. A strain of Plasmodium vivax characterized by prolonged incubation: the effect of numbers of sporozoites on the length of the prepatentperiod. Trans Roy Soc Trop Med Hyg 1976;70:474-481.
- 64. Singal M, Shaw PK, Lindsay RC, Roberto RR. An outbreak of introduced malaria in California possibly involving secondary transmission. Am J Trop Med Hyg 1977;26:1-9.
- 65. Soh CT, Lee KT, Im KI, et al. Current status of malaria in Korea. Yonsei Rep Trop Med 1985;16:11-18.
- 66. Tiburskaja NA, Vrublevskaja OS. WHO/MAL/77.895. The course of infection caused by the North Korean strain of Plasmodium vivax. 1977. p. 1-19.
- 67. Yim HW, Suh GY, Ahn YS, et al. Epidemiologic and clinical analysis of 87 indigenous malaria among Korean soldiers in 1995. Korean J Infec Dis 1996;28:219-224. (in Korean).
- 68. Xu J, Liu H. Border malaria in Yunnan, China. Southeast Asian J Trop Med Public Health 1997;28:456-459.
Fig. 1Malaria (
Plasmodium vivax) situation in 1965. Note that the residual endemic areas were Kyongsangbuk-do (Province) (A) especially northern parts and Kyonggi-do (B) especially northern and southeastern parts. (Reproduced from
Ministry of Health and Social Affairs, Korea, 1966).

Figs. 2-3A ring form (Fig. 2) and a gametocyte (Fig. 3) of
Plasmodium vivax found from the first case of the re-emerging malaria in 1993 (
Chai et al., 1994).

Fig. 4Explosively increasing numbers of re-emerging malaria cases among the Korean people by the end of 1998.

Fig. 5Re-emerging malaria in the Republic of Korea (1994-1997), showing the major outbreak areas, northern parts of Kyonggi-do (A) and Gangwon-do (B), and a tendency of expanding southwards and eastwards. The majority of cases found in areas remote from the two Provinces (A and B) were veterans recently retired from military services in the outbreak areas.

Fig. 6Recent situation of the re-emerging malaria in 1998. The major outbreak areas were still confined to the northern parts of Kyonggi-do and Gangwon-do. However, many patients occurred in remote areas also. It seems that they consisted of both veterans recently retired from military service in the outbreak areas and locally transmitted cases.

Fig. 7Seasonal incidence of malarial attacks in the Republic of Korea in 1913 (
Hasegawa, 1913) and in 1993-1996 (
Chai, 1997). The seasonal patterns are very similar each other.

Fig. 8Typical fever patterns of the re-emerging
P. vivax malaria.
A. The first case found in 1993 (
Chai et al., 1994).
B. Another case detected in 1994 (
Seo et al., 1995).

Table 1Distribution of primary malarial attacks in human experimental infections
a) with the North Korean strain of
Plasmodium vivax according to incubation periods
Table 1
|
Incubation period (month)
|
|
1 |
2 |
3 |
4 |
5 |
6 |
7 |
8 |
9 |
10 |
11 |
12 |
13 |
Total |
|
No. of patients |
19 |
|
|
|
1 |
|
|
11 |
14 |
14 |
13 |
3 |
2 |
87 |
Table 2Distribution of re-emerging P. vivax malaria cases by occupation in each year
Table 2
|
Occupation |
No. of patients in each year
|
|
1993 |
1994 |
1995 |
1996 |
1997 |
1998 |
Total |
|
soldiers |
1 |
20 |
88 |
285 |
1,156 |
2,193 |
3,743 |
|
veteransa)
|
0 |
0 |
11 |
24 |
207 |
902 |
1,144 |
|
civilians |
0 |
2 |
8 |
47 |
361 |
837 |
1,235 |
|
|
Subtotal |
1 |
22 |
107 |
356 |
1,724 |
3,932 |
6,142 |
|
|
US Army personnelsb)
|
0 |
1 |
1 |
12 |
47c)
|
46d)
|
107 |
|
|
Total |
1 |
23 |
108 |
368 |
1,771 |
3,978 |
6,249 |